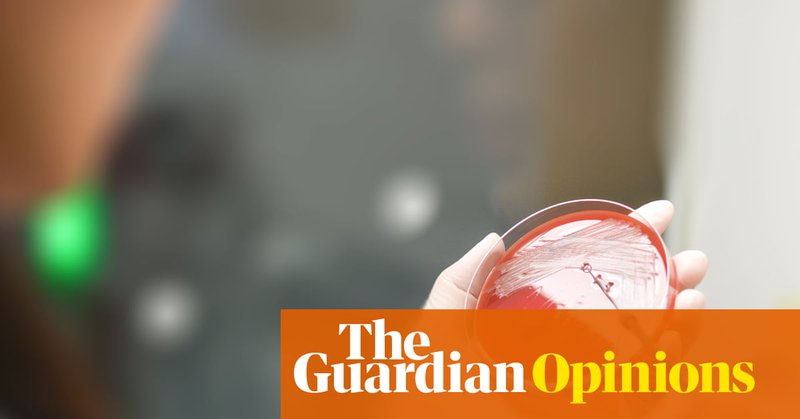

Ian Syme
@ianmsyme
Followers
1K
Following
5K
Media
6K
Statuses
139K
From Surveillance To Sedation: The Rise Of Blue Pill #Capitalism
socialeurope.eu
We are witnessing a disturbing evolution in digital capitalism—from harvesting our data to trapping us in fantasies that profit from our isolation.
0
0
0
Pets on flights can be classed as baggage, top EU court rules
theguardian.com
European court of justice asked to intervene after dog was lost on journey from Buenos Aires to Barcelona
0
0
0
While the eyes of the world are on Gaza, Israeli settlers in the West Bank still behave with impunity | Ofer Cassif
theguardian.com
As the harvest season begins, attacks on Palestinian farmers and their land are spiralling. The words of peace following the Gaza ceasefire ring hollow, says Knesset member Ofer Cassif
0
0
0
AI could make it harder to establish blame for medical failings, experts say
theguardian.com
Report raises concerns about liability issues and lack of testing as development of AI health tools booms
0
0
0
‘As new infections outpace new drugs, are we sleepwalking into a global health disaster?’ | Dr Manica Balasegaram
theguardian.com
Much of the political momentum around the antimicrobial resistance crisis has dissipated, but a new report shows the danger to our health has not
0
0
0
Towns may have to be abandoned due to floods with millions more homes in Great Britain at risk
theguardian.com
Every constituency projected to be at greater risk, with many areas likely to be uninsurable
0
0
0
Conflicts are devastating lives worldwide. Humanitarian workers - supported by the EU and guided by humanitarian principles - dedicate their lives to helping those who need it most. Hear directly from them. Hear the #VoicesOfHumanity. More: https://t.co/usTt54y73M
0
10
13
Competition law exemption ‘needed to prevent courses dying out’ Attempts to quell universities’ fears about competition laws may actually be heightening anxiety over collaboration in cash-strapped sector https://t.co/vmd68EeAev
0
2
3
High youth death rates are an ‘emerging crisis’, global health study warns
theguardian.com
Alcohol, suicide and injuries driving rises among teenagers and young adults despite overall rates falling, authors say
0
0
0
If you voted for Reform on the basis that they'd lower your council tax bills, then boy, do we have some news for you... https://t.co/WuSDezaGIJ
thelondoneconomic.com
When Reform promise you savings on your council tax bill, what else could you expect? It's not going to plan for the DOGE unit...
512
857
2K
This is the equivalent to what the German army did to the Warsaw Ghetto and then the whole of Warsaw. Collective punishment and mass destruction led to the Nuremberg Trials. They need to be staged again for today's war criminals.
4K
11K
40K
For most people, watching this clip of an actual paid agent of Putin promoting the interests of the Kremlin, will it now be possible to listen to any of Farage’s Reform politicians and not wonder who they’re really working for? https://t.co/kT1K1la61Q
71
824
2K
Israel serving as a haven for Jews from genocide won't redeem its devastated reputation after committing genocide. Redemption will come only by prosecuting the perpetrators, beginning with sending Netanyahu to the International Criminal Court.
nytimes.com
Israel’s advocates fear that its conduct of the war has cost it the support of an entire generation of U.S. voters.
107
300
778
Naughty, naughty, Welsh Water tell @Channel4News the state of the River Wye has nothing to do with them... and they're "not like the water companies in England". Well let me remind @DwrCymru that last year alone they spent 14,640 hours dumping sh*t into the Wye and as a company
64
2K
5K
Israel should pay reparations for generations - just as Germany did and does. People slaughtered for their RACE - with everything that supports life smashed into rubble — adds up to ecocide as well as genocide: the very worst crimes against humanity. No excuses.
BREAKING: First look at the aftermath in Al-Sheikh Radwan, Gaza, following the withdrawal of Israeli forces.
7K
15K
55K
“Ceasefire isn't liberation. Ceasefire isn't free Palestine... I just got back from the West Bank and the West Bank isn't Gaza. There's no H*mas in the West Bank. What I saw in the West Bank is occupation & apartheid..” —Powerful words from Irish Actress Denise Gough🔥❤️
3K
25K
86K
This is Khanyounis, where I live. Completely destroyed.
0
9K
22K
🚨NEW: The Massachusetts Institute of Technology (MIT) has rejected the Trump Administration’s offer of federal funding in exchange for aligning with Trump’s agenda. This is the first university to do so. RETWEET to thank MIT President Sally Kornbluth for standing up to Trump!
2K
15K
61K
Remember when Gary Neville opened his hotel free of charge to NHS staff who needed somewhere to stay during the early stages of lockdown. That’s surely more patriotic than hanging a flag made in China on a lamp post and painting a roundabout and screaming at mentally ill guys
680
3K
31K